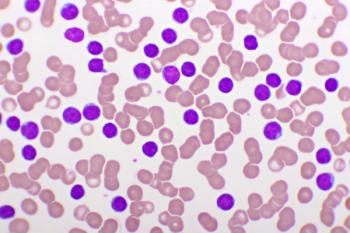

Chronic Lymphocytic Leukemia
Latest News
Latest Videos

CME Content
More News

Mazyar Shadman, MD, MPH, discusses the continued efficacy of zanubrutinib in patients with chronic lymphocytic leukemia.

AI-powered drug response prediction technology is revolutionizing veterinary and human oncology by enabling personalized treatment plans through live cell testing, machine learning models, and data-driven precision medicine approaches.

Anthony Perissinotti, PharmD, BCOP, discusses unmet needs and trends in managing chronic lymphocytic leukemia (CLL), with an emphasis on the pivotal role pharmacists play in supporting medication adherence and treatment decisions.

Zanubrutinib demonstrated sustained responses in patients with relapsed/refractory (R/R) chronic lymphocytic leukemia or small lymphocytic lymphoma (CLL/SLL).

Experts debate over the most effective treatment pathway for Richter transformation, highlighting the risks and benefits of different cellular therapies.

Alessandra Ferrajoli, MD, discusses the importance of renal function for BCL2 inhibitors to avoid tumor lysis syndrome and cardiovascular history for BTK inhibitors to mitigate arrhythmia risks.

The indication is for adults with relapsed or refractory chronic lymphocytic leukemia or small lymphocytic lymphoma who were treated with at least 2 prior lines of therapy.

This article discusses clinical data for noncovalent Bruton tyrosine kinase inhibitors (BTKis), novel strategies in CLL, and the practical management of BTKi toxicities.

Acalabrutinib plus venetoclax, with or without obinutuzumab, demonstrated significant improvements in progression-free survival.

The drug previously received breakthrough therapy designation for newly diagnosed Philadelphia chromosome-positive chronic myeloid leukemia that is in chronic phase.

Increased immunoglobulin replacement therapy led to reduced infections and managed secondary immune deficiencies such as hypogammaglobulinemia.

Follow-up data reveal 10-year impact of ibrutinib in treatment of patients with chronic lymphocytic leukemia or small lymphocytic lymphoma (CLL/SLL).

An increased frequency of immunoglobulin G testing in patients with chronic lymphocytic leukemia (CLL) and non-Hodgkin lymphoma (NHL) was also associated with a lower likelihood of severe infections.

Zanubrutinib shows potential in treating patients with treatment-naïve high-risk chronic lymphocytic leukemia and/or small lymphocytic lymphoma with del(17p) and/or TP53 mutation.

This article provides an overview of data supporting the utility of covalent Bruton tyrosine kinase inhibitors in chronic lymphocytic leukemia and details important considerations when choosing among agents.

The indication is for adult patients who have received at least 2 prior lines of systemic therapy and is based on the response rate and duration of response shown in a phase 2 trial.

This review discusses the prevalence, mechanisms of development, and evolving treatment landscape in chronic lymphocytic leukemia.

The results demonstrated similar overall survival between patients with chronic lymphocytic leukemia who discontinued specialized follow-ups versus those who continued.

In a phase 1/2 clinical trial, lisocabtagene maraleucel helped patients with chronic lymphocytic leukemia (CLL) or small lymphocytic lymphoma (SLL) achieve complete response rates.

Certain patients may present asymptomatically, affecting treatment options.

Treatment options are distinct in their mechanisms, safety profiles, and implications for patients’ quality of life.

Approximately 41% of enrolled patients responded to NX-2127, and the BTK degrader overcame resistance to nearly all BTK mutations that were identified to cause resistance.
The MRD-guided treatment approach has a significant advantage over chemotherapy.

Kyle Farina, PharmD, BCPS, BCOP, addresses the multifaceted role of pharmacists in CLL management, including their role in patient care, treatment decision support, and addressing safety considerations.

Presentations detail clinical trial results and focus on drugs in the pipeline.






























